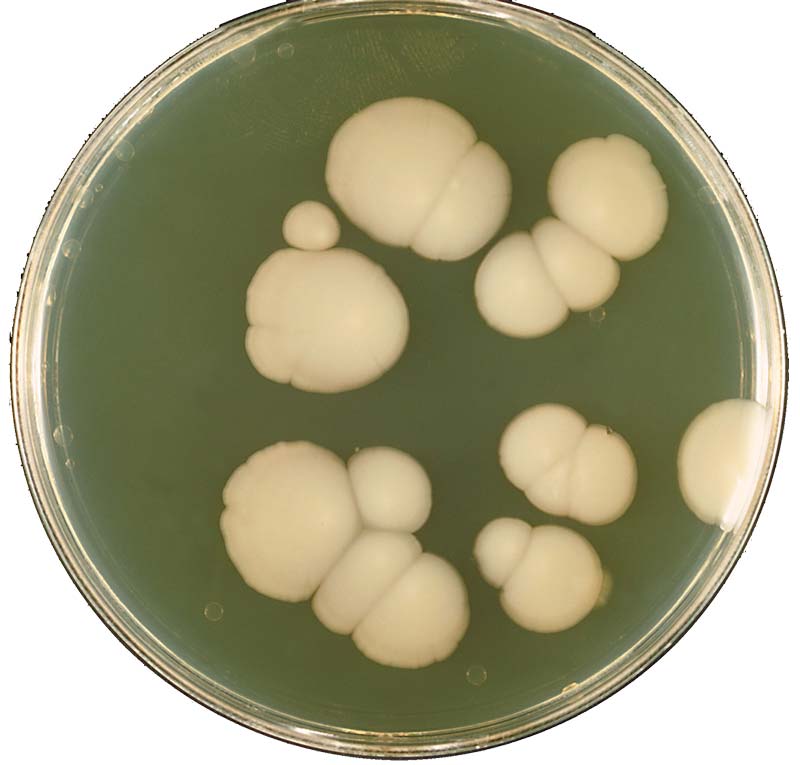

Candida infections have become an epidemic problem because of the overuse and misuse of antibiotics. The modern diet is another big problem, and bad dietary choices turn our bodies into the perfect environment for Candida overgrowth.
Chapter 1: Learn what Is Candida and why Should You Worry about it
Candida overgrowth is the main reason for many health issues, although the idea is not part of the mainstream medical care. It is estimated that about 75% of women had at least one Candida overgrowth during their lifetime. A Candida problem episode is not a big concern, if taken out of the context. But usually an external Candida outbreak means there is a problem in the inside too.
Candida – You Might Have It Too
Don’t think you don’t have a problem with Candida, not just until you read this. Most people with systemic fungal candida can go decades without any major symptoms. In all this time a slow but certain degeneration of the body’s cells and tissues advances.
In this guide, you will learn all about Candida. You will also learn several practical ways to treat Candida infections and prevent Candida from becoming a problem for you and your family. Prevention is always better than cure.

Contrary to popular thinking, candidiasis is not just a simple infection, but rather a symptom of a disordered immune system. It has characteristics of infection, but there is more to it than that. Invariably various other aspects are involved, such as food and chemical sensitiveness, sensitive hypoglycemia, trace-mineral inequality, collections of dangerous materials, allergy to the fungus itself, mental and other tensions, or even soft tissue imbalance. Age is also a factor that makes us more prone to Candida infections.
Humans have learned the hard way that once you destroy the ecological balance of nature is very hard to rebuild it. Now, nations from all over the world collaborate towards building a sustainable economy that protects the environment. What the economy has to do with Candida infections, you might ask… Well, our body is, at a small scale, a replica of the Earth. There are many species that populate it, that interact, and they have to be in a perfect balance. If we poison our body, we change its chemistry and some microorganisms will thrive in the poisoned environment, and some other will decline. Candida infections are the result of destroying the ecology of the microbiome.
There are many books on Candida, my two favorites are The Everything Candida Diet Book by Jeffrey McCombs, and The Candida Cure by Ann Boroch. How is my guide better than the two, and other Candida books? My guide is more condensed, it lacks the fluff, and it’s more practical. You can take action right away. And it’s free.
What Is Candida

Candida is the scientific name for a type of yeast that lives in the human body. At low count levels, this yeast is part of the normal biome and doesn’t cause any health issues. However, under certain conditions, Candida can grow uncontrollably and become harmful. Candida infections can cause a whole host of health issues from mild to severe.
There are hundreds of species of Candida, with at least a dozen living in our body. The most abundant Candida species in the body is Candida albicans and most of the medical research on Candida has been focused on this species. However, more recent research has begun to look at the negative effects of other Candida species: C. glabrata, C. parapsilosis, C. tropicalis, C. krusei, and other, known to do harm to humans as well. You will likely hear more about these species in the near future.
Many of us have had a Candida problem, and we might still have it, but we don’t know it. Fatigue without a reason, or constantly craving sugar are common symptoms. With any of these two symptoms you can take the first step of the anti Candida program, and stop eating sugar and drinking alcohol. More about these later in the guide… I will also show you the best ways to kill this pesky yeast. If you need to start with antifungals now, here are my recommendations: garlic, and fatty acids. The best fatty acids for killing yeast are Caprylic acid, and Undecenoic acid, (or undecylenic acid). Not all fatty acids are the same, the products I recommend are among the best.
Causes and Symptoms of Candida Overgrowth
Here is a video interview with naturopath Ann Boroch. She explains in the interview how Candida can affect us, and why she believes yeast infections are the cause of many modern ailments.
In the next chapter of this eBook, we will discuss about diagnosing Candida, and why is it so hard to diagnose it. Some of the symptoms are so common that you would never think it’s yeast overgrowth…
There are many books on Candida, my two favorites are The Everything Candida Diet Book by Jeffrey McCombs, and The Candida Cure by Ann Boroch. How is my guide different than the two, and other Candida books? My guide is more condensed, and more practical. You can take action right away. Sure, the books have more information, and for someone that needs to perfectly understand their condition, the books are better. However, you can read my plan first, and if you need more information, then read the books.
What Is Candida and Why Should We Worry about It?
You actually explained it exceptionally well!